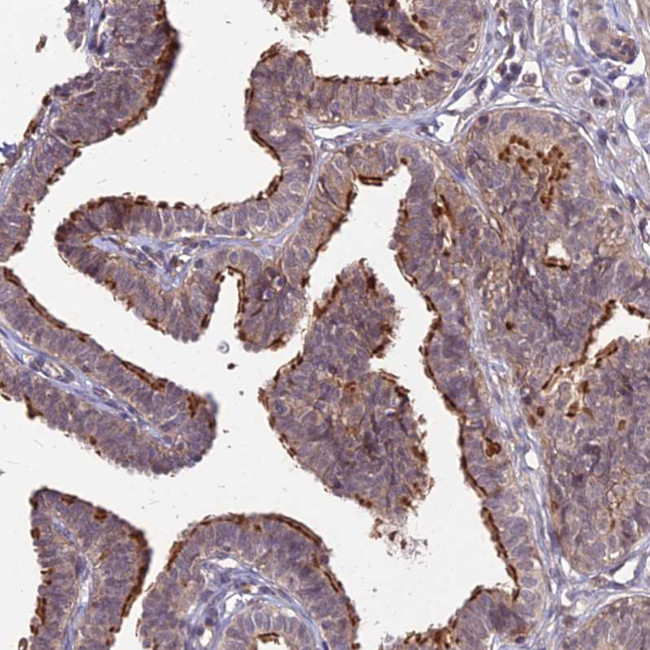
MINT3 Antibody in Immunohistochemistry (Paraffin) (IHC (P))

Search
Invitrogen
MINT3 Polyclonal Antibody
{{$productOrderCtrl.translations['antibody.pdp.commerceCard.promotion.promotions']}}
{{$productOrderCtrl.translations['antibody.pdp.commerceCard.promotion.viewpromo']}}
{{$productOrderCtrl.translations['antibody.pdp.commerceCard.promotion.promocode']}}: {{promo.promoCode}} {{promo.promoTitle}} {{promo.promoDescription}}. {{$productOrderCtrl.translations['antibody.pdp.commerceCard.promotion.learnmore']}}
产品信息
PA5-61037
种属反应
宿主/亚型
分类
类型
抗原
偶联物
形式
浓度
规格
纯化类型
保存液
内含物
保存条件
运输条件
RRID
产品详细信息
Immunogen sequence: QFEALPGDLV GPSPGGAPCP LHIATGHGLA SQEIADAHGL LSAEAGRDDL LGLLHCEECP PSQTGPEEPL EPAPRLLQP
Highest antigen sequence identity to the following orthologs: Mouse - 70%, Rat - 68%.
靶标信息
The munc-18 interacting protein (Mint) protein family is a group of evolutionarily conserved adaptor proteins that function in membrane transport and organization. In mammals, there exist three mint isoforms, Mint1, 2, and 3. Although there is little amino acid sequence conservation in the amino-terminal half, the carboxy-terminal half of these proteins is highly conserved. Within this conserved portion there exists a phosphotyrosine-binding (PTB) and a PSD-95/DLG-A/ZO-1 (PDZ) domain, which function as protein interaction modules. Mint1 and 2 appear to be expressed exclusively in the brain and are found to bind to Munc18, an essential component of the synaptic vesicle fusion machinery. Mint3 is ubiquitously expressed in all tissues and is expressed at the lowest levels in the brain and testis. Studies show that mint3 does not interact with munc-18. Mint3 has been found to interact with the Alzheimer's Disease-related amyloid precursor protein (APP) and does so through its PTB and PDZ domains. It has been suggested that mint3 links APP to other transport machinery components, thereby regulating it transport, endocytosis, and metabolism. Abnormal APP metabolism has been shown to be the cause of an early-onset type of Alzheimer's disease.
仅用于科研。不用于诊断过程。未经明确授权不得转售。
篇参考文献 (0)
生物信息学
蛋白别名: Adapter protein X11gamma; amyloid beta (A4) precursor protein-binding, family A, member 3 (X11-like 2); Amyloid-beta A4 precursor protein-binding family A member 3; lin 10; Mint-3; Neuron-specific X11L2 protein; Neuronal Munc18-1-interacting protein 3; phosphotyrosine-binding/-interacting domain (PTB)-bearing protein; X11-like 2 protein
基因别名: APBA3; MGC:15815; MINT3; X11L2
UniProt ID: (Human) O96018
Entrez Gene ID: (Human) 9546